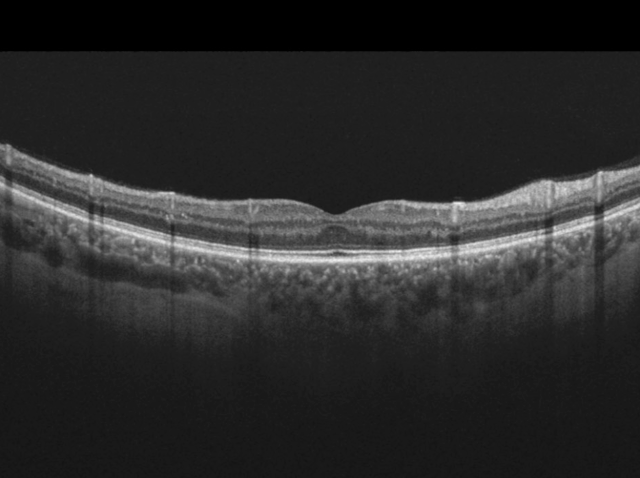

AI Applied to Medicine

The ROVIT Research Group investigates how Artificial Intelligence (AI) can transform healthcare by developing advanced tools that assist medical professionals, improve patient outcomes, and drive innovation in clinical practice. Our research focuses on creating intelligent systems that enhance diagnosis, treatment planning, monitoring, and decision-making in diverse medical contexts
Research Objectives
Medical Imaging and Diagnosis
Apply deep learning and computer vision to detect, classify, and analyze medical images for early and accurate diagnosis.
Patient Monitoring
Leverage wearable devices, IoT, and predictive analytics to track patient health and anticipate critical events.
Treatment Support
Develop AI-based systems to recommend personalized treatment plans and assist clinicians in surgical or therapeutic procedures.
Healthcare Workflow Optimization
Introduce intelligent assistants to support clinicians in documentation, triage, and resource allocation.
Deep Learning models for medical image segmentation, detection, and classification.
Natural Language Processing (NLP) for electronic health records (EHR) analysis and clinical note summarization.
Predictive analytics for patient risk assessment and personalized treatment recommendations.
Reinforcement Learning for optimizing therapeutic protocols and robotic-assisted interventions.
Multimodal AI combining images, text, and sensor data for holistic healthcare analysis.
Applications
Impact
Our work contributes to safer, more efficient, and patient-centered healthcare systems. By applying AI to medicine, we aim to reduce diagnostic errors, support medical professionals in complex decision-making, and bring cutting-edge innovations to patient care. Ultimately, our research seeks to improve quality of life and accessibility to healthcare worldwide.